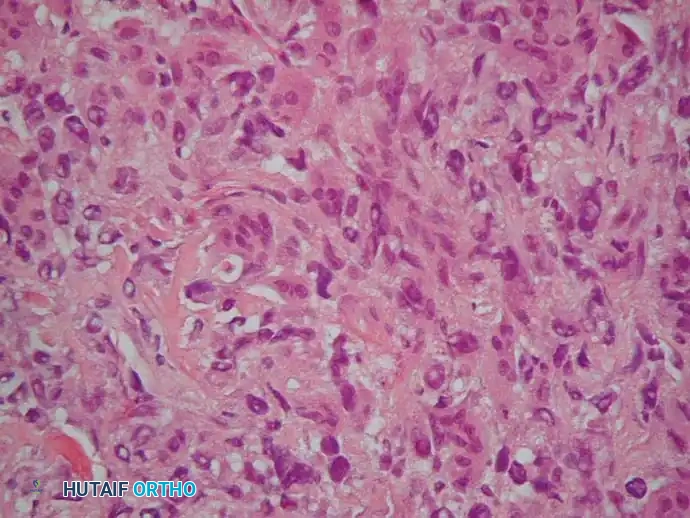
Image

Malignant Tumors of Bone: Osteosarcoma
Osteosarcoma is an aggressive, high-grade malignancy characterized by the direct production of osteoid or immature bone by malignant mesenchymal cells. Excluding multiple myeloma, it stands as the most common primary malignancy of bone, accounting for approximately 20% of all primary bone sarcomas. The management of osteosarcoma represents one of the greatest triumphs of modern orthopedic oncology, evolving from a disease treated almost exclusively with amputation—yielding a dismal 20% survival rate—to a paradigm of limb-salvage surgery and multiagent chemotherapy with long-term survival rates approaching 70% to 75% for localized disease.
Epidemiology and Genetic Factors
The incidence of osteosarcoma is approximately 1 to 3 per 1 million individuals annually. The disease exhibits a classic bimodal age distribution. Primary high-grade conventional osteosarcoma occurs most frequently in the second decade of life, coinciding with the adolescent growth spurt. A second peak occurs in patients over the age of 50, typically representing secondary osteosarcomas arising in the setting of Paget disease, prior irradiation, or bone infarcts.
While most cases are sporadic, genetic predispositions play a critical role in a subset of patients. Mutations in tumor suppressor genes are heavily implicated:
* Retinoblastoma (Rb) Gene: Patients with hereditary retinoblastoma have a significantly elevated risk of developing osteosarcoma.
* Li-Fraumeni Syndrome: An autosomal dominant condition caused by a germline mutation in the TP53 gene, predisposing individuals to osteosarcoma, breast cancer, and soft-tissue sarcomas.
* Rothmund-Thomson Syndrome: An autosomal recessive disorder associated with skeletal dysplasias and a high risk of osteosarcoma.
Clinical Presentation and Diagnostic Pitfalls
Osteosarcoma most commonly arises in the metaphyseal regions of long bones, sites of the most rapid bone turnover. The distal femur, proximal tibia, and proximal humerus account for the vast majority of cases.
Patients typically present with progressive, deep, and aching pain. This pain results from microinfarctions and periosteal stretching as the invasive tumor cells weaken the involved bone and expand outward.
Clinical Pearl: Pain initially may improve with conservative measures, rest, and activity modifications. This transient improvement frequently leads to a false sense of security for both the patient and the physician, resulting in catastrophic diagnostic delays.
Night pain or pain at rest is a classic hallmark, though it is reported in only about 25% of patients. A palpable soft-tissue mass may be present if the tumor has breached the cortex.
The average delay from the onset of symptoms to the correct diagnosis is alarmingly high—approximately 15 weeks. This delay is often compounded by the failure to obtain initial radiographs or, more critically, the failure to repeat radiographs when a patient’s symptoms persist despite conservative management.
Imaging and Staging
Thorough radiographic evaluation is the cornerstone of diagnosis and surgical planning.
Plain Radiographs: Plain films remain the most valuable initial tool. The classic appearance is an aggressive, permeative, ill-defined lesion in the metaphysis. The lesion may be osteoblastic (sclerotic), osteolytic, or mixed. Periosteal reactions are common and indicate rapid tumor growth breaking through the cortex. Classic signs include "Codman’s triangle" (elevation of the periosteum at the tumor margin) and a "sunburst" or "hair-on-end" appearance caused by ossification along Sharpey's fibers.

Anteroposterior and lateral radiographs demonstrating a highly aggressive, mixed lytic and blastic osteosarcoma in the distal femur of a 31-year-old man, with cortical destruction and soft-tissue extension.

Anteroposterior view of the proximal humerus in an 8-year-old boy with osteoblastic osteosarcoma, alongside an MRI demonstrating the extensive intramedullary and soft-tissue involvement.
Magnetic Resonance Imaging (MRI): MRI of the entire involved bone is mandatory. It is the gold standard for determining the intraosseous extent of the tumor, identifying "skip metastases" (distinct tumor foci within the same bone), and delineating the relationship of the soft-tissue mass to critical neurovascular structures.
Systemic Staging:
* CT of the Chest: The lungs are the most common site of metastasis. High-resolution CT is required to detect pulmonary micrometastases.
* Bone Scan / PET-CT: Utilized to detect skeletal metastases.
Histological Subtypes and Pathology
Osteosarcomas are broadly categorized into primary and secondary lesions, with primary tumors further subdivided based on their location (intramedullary vs. surface) and histological grade.
Conventional Osteosarcoma
Accounting for the vast majority of cases, conventional osteosarcoma is a high-grade, intramedullary tumor. Histologically, it is characterized by highly pleomorphic spindle cells producing malignant osteoid. It can be subclassified into osteoblastic, chondroblastic, or fibroblastic variants, though the clinical behavior and treatment remain identical.


Low-power and high-power photomicrographs showing hypercellular malignant spindle cells producing delicate, lace-like malignant osteoid.
Further histological detail demonstrating marked nuclear pleomorphism and abundant mitotic figures typical of high-grade conventional osteosarcoma.
Parosteal Osteosarcoma
Parosteal osteosarcoma is a low-grade, surface-based malignancy that typically arises on the posterior aspect of the distal femur. It grows indolently and invades the medullary canal only in late stages.

Anteroposterior and lateral radiographs of a parosteal osteosarcoma arising in its classic location on the posterior distal femur.


CT and MRI scans confirming the lesion arises from the cortical surface without initial involvement of the medullary cavity. CT is particularly useful in differentiating this from myositis ossificans, as parosteal osteosarcoma is more heavily ossified in the center.


Microscopic appearance of parosteal osteosarcoma showing slightly atypical spindle cells producing relatively mature, normal-appearing bony trabeculae.
Periosteal Osteosarcoma
An intermediate-grade surface malignancy, periosteal osteosarcoma most commonly affects the diaphyses of the femur and tibia. It presents with a prominent cartilaginous component.

Radiographs of the proximal femur in a 67-year-old woman with periosteal osteosarcoma.

MRI showing the lesion arising from the surface of the bone, with the marrow cavity spared.


Gross specimen after wide resection (left) and cut specimen (right) clearly demonstrating the surface origin and lack of medullary involvement.

Histology of periosteal osteosarcoma: lobules of malignant cartilage separated by malignant spindle cells producing osteoid.
Telangiectatic and Small Cell Variants
- Telangiectatic Osteosarcoma: A purely lytic, destructive lesion that grossly resembles a blood-filled aneurysmal bone cyst (ABC). Microscopically, the septa separating the blood-filled spaces contain highly malignant, osteoid-producing cells.
- Small Cell Osteosarcoma: A rare, high-grade variant composed of small blue round cells, often requiring immunohistochemistry to differentiate from Ewing sarcoma or lymphoma.
Secondary Osteosarcoma
Constituting nearly half of osteosarcomas in patients over 50, these arise in abnormal bone. Paget disease carries a 1% risk of malignant transformation (higher in polyostotic disease). Radiation-induced osteosarcoma occurs in approximately 1% of patients treated with >2500 cGy, typically presenting 10 to 15 years post-exposure.
Surgical Management: Principles of Limb Salvage
The standard of care for high-grade osteosarcoma is neoadjuvant (preoperative) chemotherapy, followed by wide surgical resection, and concluding with adjuvant chemotherapy.
Surgical Warning: The biopsy is the first and most critical step in surgical management. The biopsy tract must be meticulously planned so that it can be excised en bloc with the tumor during definitive resection. Poorly placed biopsies can contaminate neurovascular bundles or extensive soft tissue, converting a limb-salvage candidate into an obligate amputee.
Indications for Limb Salvage:
1. The tumor can be resected with negative (wide) oncologic margins.
2. The limb can be reconstructed to provide function superior to, or equal to, a prosthesis following amputation.
3. The neurovascular bundle is free of tumor involvement (though isolated vascular involvement can sometimes be managed with bypass grafting).
Preoperative Planning and Biomechanics of Reconstruction
Endoprosthetic reconstruction is the most common method for limb salvage following resection of the distal femur or proximal tibia.
Biomechanics of Hinged Knee Prostheses:
Resection of the distal femur necessitates the removal of the collateral and cruciate ligaments. Therefore, a constrained, hinged knee prosthesis is required. Modern rotating-hinge designs allow for flexion/extension as well as internal/external rotation. This rotational freedom is critical; it dissipates torsional forces that would otherwise be transmitted directly to the stem-bone interface, significantly reducing the risk of aseptic loosening.
Stems may be cemented or press-fit (biologic fixation). Cemented stems provide immediate stability and allow for early weight-bearing, which is advantageous in patients undergoing aggressive chemotherapy. Press-fit stems rely on extracortical bone bridging and osteointegration, offering potentially greater long-term durability in young, active patients.
Step-by-Step Surgical Approach: Distal Femur Resection and Reconstruction
1. Positioning and Preparation:
The patient is positioned supine. A bump is placed under the ipsilateral hip to prevent external rotation. The limb is prepped and draped free. A sterile tourniquet is applied high on the thigh but is generally not inflated unless severe hemorrhage occurs, as ischemia can complicate the identification of tumor margins and viable tissue.
2. Surgical Approach:
An extensile anteromedial or anterolateral approach is utilized, incorporating the previous biopsy tract in an elliptical incision. The incision extends from the mid-thigh down to the tibial tubercle.
3. Neurovascular Isolation:
The superficial femoral artery and vein are identified in the subsartorial canal (Hunter's canal) proximal to the tumor. They are meticulously dissected distally through the popliteal fossa, ensuring a cuff of normal tissue (usually muscle or fat) is maintained over the tumor capsule.
4. Osteotomy and Resection:
Based on preoperative MRI, the femoral osteotomy site is measured (typically 3 to 5 cm proximal to the most proximal extent of the marrow edema/tumor). The femur is transected using an oscillating saw. The distal femur is then mobilized, dividing the collateral ligaments, joint capsule, and cruciate ligaments to remove the tumor en bloc.

Photograph of the resected distal femur specimen alongside the modular endoprosthetic implant prepared for reconstruction.
5. Reconstruction:
The femoral canal is reamed to accommodate the prosthetic stem. If using cement, a cement restrictor is placed, the canal is pulsatile lavaged, and PMMA bone cement is injected retrograde. The femoral component is impacted. The proximal tibia is then prepared with a standard tibial cut, and the tibial component is cemented into place. The rotating hinge mechanism is assembled.

Intraoperative photograph demonstrating the modular rotating-hinge endoprosthesis in situ, restoring the length and mechanical axis of the lower extremity.
6. Soft Tissue Coverage and Closure:
Adequate soft-tissue coverage is paramount to prevent infection and implant exposure. The extensor mechanism is repaired. If the local soft tissue is compromised, a medial gastrocnemius rotational flap may be required to cover the prosthesis. The wound is closed in layers over suction drains.
Postoperative Protocols and Rehabilitation
Postoperative management requires close coordination between the orthopedic oncologist and the medical oncologist.
Immediate Postoperative Phase:
* Weight-Bearing: Patients with cemented prostheses are typically allowed immediate weight-bearing as tolerated in a hinged knee brace locked in extension. Press-fit stems may require restricted weight-bearing for 6 weeks to allow for osteointegration.
* VTE Prophylaxis: Aggressive chemical prophylaxis is mandatory due to the hypercoagulable state of malignancy and major orthopedic surgery.


Postoperative anteroposterior and lateral radiographs confirming excellent alignment and fixation of the distal femoral replacement.
Adjuvant Chemotherapy and Pathologic Evaluation:
Adjuvant chemotherapy typically resumes 2 to 3 weeks postoperatively, once wound healing is assured. The resected specimen is sectioned and mapped by pathology to determine the percentage of tumor necrosis—a critical prognostic indicator known as the Huvos grade.
Clinical Pearl: A tumor necrosis rate of ≥90% (Huvos Grade III or IV) indicates a good response to neoadjuvant chemotherapy and correlates with a significantly higher rate of long-term disease-free survival.
Prognosis and Survival
The most critical prognostic factor at the time of diagnosis is the presence of metastatic disease. Approximately 15% to 20% of patients present with detectable pulmonary metastases.
- Localized Disease: With modern multiagent chemotherapy (typically High-Dose Methotrexate, Doxorubicin, and Cisplatin - MAP regimen) and wide surgical resection, long-term survival is 60% to 75%.
- Metastatic Disease: Patients with macroscopic pulmonary metastases at presentation have a poorer prognosis (<20% long-term survival). However, patients with a limited number of resectable pulmonary nodules who undergo aggressive pulmonary metastasectomy can achieve survival rates exceeding 30% to 40%.
- Low-Grade Variants: Patients with low-grade lesions (e.g., parosteal osteosarcoma) treated with wide resection alone enjoy survival rates approaching 90%.
Continuous long-term surveillance with serial chest CTs and local radiographs is mandatory, as late recurrences, implant wear, and aseptic loosening remain lifelong risks for the orthopedic oncology patient.
📚 Medical References
- of the limb: amputation or limb salvage in patients treated by neoadjuvant chemotherapy, J Bone Joint Surg 84B:88, 2002.
- Bacci G, Ferrari S, Longhi A, et al: Nonmetastatic osteosarcoma of the extremity with pathologic fracture at presentation: local and systemic control by amputation or limb salvage after preoperative chemotherapy, Acta Orthop Scand 74:449, 2003.
- Bacharach JM, Rooke TW, Osmundson PJ, et al: Predictive value of transcutaneous oxygen pressure and amputation success by use of supine and elevation measurements, J Vasc Surg 1:558, 1992.
- Baker WH, Barnes RW, Shurr DG: The healing of below-knee amputations: a comparison of soft and plaster dressings, Am J Surg 133:716, 1977.
- Baptista A, Barros MA, Azenha A: Allergic contact dermatitis on an amputation stump, Contact Dermat 26:140, 1992.
- Barbera J, Albert-Pamplo R: Centrocentral anastomosis of the proximal nerve stump in the treatment of painful amputation neuromas of major nerves, J Neurosurg 79:331, 1993.
- Belcher H, Pandya A: Centro-central union for the prevention of neuroma formation after fi nger amputation, J Hand Surg 25B:154, 2000.
- Benevenia J, Makley JT, Leeson MC, et al: Primary epiphyseal transplants and bone overgrowth in childhood amputations, J Pediatr Orthop 12:746, 1992.
- Bhagia SM, Elek EM, Grimer RJ, et al: